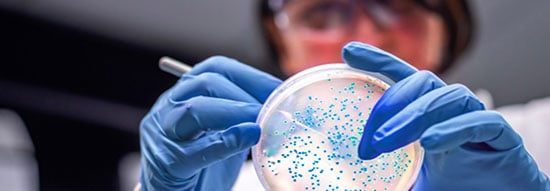

In the rapidly evolving world of cell and gene therapy, speed, precision, and reliability are non-negotiable. For biotech innovators and established pharmaceutical companies alike, the journey from early-stage discovery to commercial manufacturing can feel like navigating uncharted territory. That’s where Charles River comes in.
As a trusted CDMO (Contract Development and Manufacturing Organization) and CRO (Contract Research Organization), Charles River has supported the development of more than 75% of cell and gene therapies approved by the FDA between 2019 and 2023. With a legacy spanning over 75 years, their scientific expertise, regulatory insight, and robust portfolio of solutions have helped countless therapy developers bring their vision from research-grade concepts to commercial-scale production.
Now, through the ZAGENO marketplace, researchers can access a broad selection of Charles River’s gold-standard reference materials, packaging plasmids, and custom viral vector services—making it easier than ever to source the products and services that can accelerate therapeutic breakthroughs.
Why Partner with Charles River for Cell and Gene Therapy Development?
Gene therapy holds incredible promise to address diseases once thought untreatable. However, the complexity of this field—from regulatory hurdles to the intricacies of viral vector manufacturing—creates risks that can derail even the most promising therapeutic.
Charles River is uniquely positioned to help developers overcome these challenges. Their integrated, end-to-end approach empowers researchers and manufacturers to:
- Begin with the end in mind by planning for scalability and regulatory compliance from day one.
- Access gold-standard reference materials for reliable assay development and quality control.
- Simplify supply chains with readily available, royalty-free packaging plasmids.
- Leverage custom viral vector packaging services tailored to each unique construct.
- Confidently scale up into GMP production with expert guidance at every stage.
By combining scientific rigor with regulatory expertise, Charles River helps therapy developers reduce costly late-phase risks and move toward commercialization with confidence. Looking to explore additional tools? Visit our collection of cell and gene therapy resources to see how ZAGENO supports research teams end-to-end.
Gold Standard AAV Reference Materials
One of the most significant barriers in gene therapy research is ensuring accuracy and reproducibility during assay development. Charles River addresses this need through their gold-standard AAV (adeno-associated virus) reference materials, which are now available for purchase on ZAGENO.
These pre-made, well-characterized reference materials are available in both empty and full capsids. They can be applied across a wide range of research and quality control workflows, including:
- qPCR titer assays
- ELISA testing
- HPLC assays
- Vector characterization
- Assay controls
By starting with trusted reference materials, researchers reduce variability, gain confidence in their results, and accelerate the path to meaningful discoveries.
Off-the-Shelf Packaging Plasmids
When speed is critical, off-the-shelf availability becomes a game-changer. Charles River provides AAV and LVV (lentiviral vector) packaging plasmids that are fit-for-purpose, royalty-free, and always ready to ship.
The portfolio includes both:
- pHelper plasmids
- REP/CAP plasmids
These plasmids are optimized for reliable performance and are license-free, ensuring that researchers avoid hidden costs or downstream licensing barriers. By sourcing them directly through ZAGENO, labs can streamline procurement and reduce delays—whether for small-scale experiments or larger studies.
Custom Viral Vector Packaging for Any Construct
Every therapeutic candidate is unique, and success often hinges on tailored solutions. Charles River offers custom viral vector packaging services, giving researchers the flexibility to design and scale vectors that match their specific requirements.
Options include a broad range of:
- Vectors (AAV, LVV, and others)
- Promoters
- Transgenes

These services are available for every stage of research, from early in vitro assays to non-human primate (NHP) studies. With multiple scales offered, labs can seamlessly transition from proof-of-concept experiments into preclinical and clinical development.
Easily Scale-Up into GMP Production
Moving from research to clinical development is a critical—and often costly—inflection point for therapy developers. Many programs stall due to unforeseen scalability challenges, inconsistent manufacturing processes, or regulatory hurdles.
Charles River helps developers avoid these late-stage pitfalls by offering a comprehensive concept-to-cure portfolio. With deep expertise in GMP (Good Manufacturing Practice) production, they provide the technical guidance and infrastructure needed to scale therapies reliably and safely.
This includes:
- Process development support for seamless scale-up.
- GMP-compliant manufacturing services.
- Regulatory expertise to ensure compliance at every step.
- Supply chain reliability to minimize disruptions.
With Charles River, researchers can move forward knowing they have a trusted partner for the entire therapeutic journey—from discovery to commercial manufacture.
The Charles River Advantage: Over 75 Years of Experience
Few organizations in the life sciences industry bring the breadth of experience that Charles River does. For more than 75 years, they have been a trusted partner to pharmaceutical and biotech companies, offering not just products and services but also the guidance and collaboration needed to succeed.
Their impact on the gene therapy field speaks for itself: from 2019 to 2023, they supported the development of over 75% of FDA-approved cell and gene therapies. This unmatched track record makes them a partner of choice for developers looking to navigate the complexities of this growing space.
Access Charles River Products Directly Through ZAGENO
One of the biggest challenges labs face is procurement inefficiency. Multiple suppliers, varied lead times, and fragmented ordering systems can slow down R&D progress. That’s why making Charles River products available on the ZAGENO marketplace is such a powerful solution.
Through ZAGENO, researchers can:
- Consolidate purchasing into one streamlined platform.
- Easily compare and source essential products.
- Access Charles River’s reference materials, plasmids, and services alongside thousands of other suppliers.
- Simplify procurement and focus more on science, not paperwork.
Final Thoughts: Partnering for the Future of Gene Therapy
The future of medicine is increasingly being shaped by cell and gene therapies—treatments that were once considered impossible are now reaching patients worldwide. But realizing that future requires the right partnerships, expertise, and resources.
With Charles River’s end-to-end solutions, researchers can:
- Accelerate discovery with gold-standard AAV reference materials.
- Simplify procurement with off-the-shelf plasmids.
- Customize viral vectors for any construct or scale.
- Confidently scale into GMP manufacturing with expert guidance.
And with ZAGENO providing a seamless procurement platform, it has never been easier to access these tools and services that can transform research into real-world therapies.
Learn more about Charles River’s portfolio at Charles River Laboratories or explore their offerings directly on theZAGENO marketplace.
Because in gene therapy development, every decision matters—and with Charles River and ZAGENO, you gain partners who help you make the right ones.


